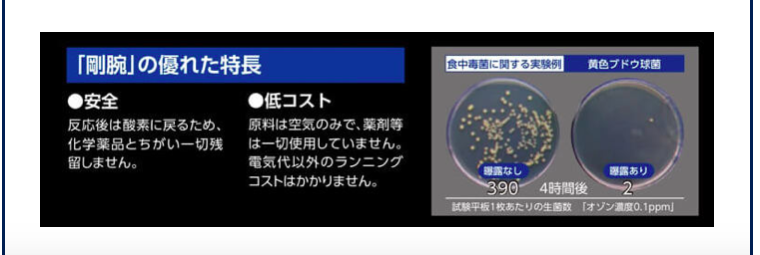

LEXUS NX350h 室内消臭
LEXUS NX350h 室内消臭にて、ご入庫いただきました。

室内消臭の施工をしていきます。

お客様よりエアコンを使用した際に異臭がするとの、ご依頼をうけました。
車両のシガーソケットより電源を供給し専用の機械を助手席の足元に設置します。

こちらの機械はオゾンを発生させ臭いを分解し無臭にします。
ホテルでの導入実績もNo.1で施工した際の効果は絶大です。

こちらはオゾン発生器を使用した実験結果です。
オゾン発生器を使用することで菌が99%消滅しております。
併せてカーメイトさんのDr.DEOを使用し除菌も行い室内の臭いを徹底的に無くします。


除菌施工後はドア等を開け換気します。

最後にPITWORKの、わさびd’airをエアコンフィルターに設置しエアコン稼働中の除菌もしていきます。


この度は、ご入庫いただき誠にありがとうございました。
